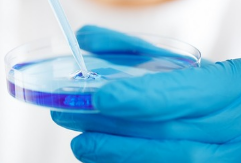
신라젠 주가 전망 | 신라젠(SJ-607) 국내 특허 등록! 주가 상승 기대?

신라젠(215600)이 자사의 항암바이러스 플랫폼 SJ-600 시리즈 중 ‘SJ-607’의 국내 특허 등록에 성공하며, 바이오 업계에서 주목받고 있습니다. 이번 특허 등록은 항암바이러스 기술의 독창성과 안정성을 인정받았다는 점에서 의미가 큽니다.
이번 성과는 신라젠 주가에도 중요한 영향을 미칠 요소로 작용할 수 있습니다. 바이오 기업의 경우, 핵심 기술에 대한 특허 획득과 임상 진행 상황이 기업 가치를 결정하는 중요한 요인 중 하나이기 때문입니다. 이에 따라, 신라젠 주가 전망과 향후 기업 전략에 대한 관심이 높아지고 있습니다.
신라젠
SillaJen is a privately-held biotechnology company focused on engineering and developing best-in-class oncolytic virus immunotherapeutics. A global leader in oncolytic immunotherapeutics Targeting, Attacking and Eradicating Cancers
www.sillajen.com
이번 글에서는 신라젠 항암바이러스 플랫폼 SJ-607의 핵심 기술, 특허의 의미, 글로벌 시장 진출 가능성, 그리고 신라젠 주가 전망까지 심층 분석해 보겠습니다.

신라젠 SJ-607 항암바이러스 플랫폼
SJ-607은 신라젠이 독자적으로 개발한 항암바이러스 플랫폼(GEEV® Platform)으로, 신라젠의 다른 항암 치료제 개발의 핵심 기술 기반이 되는 플랫폼입니다. 이번 특허의 핵심 기술은 보체조절단백질을 표면에 발현하는 항암 바이러스로, 이를 통해 정맥 투여 시에도 바이러스의 안정성을 높일 수 있습니다.
1. SJ-607의 주요 특징
✅ 보체조절단백질 CD55를 바이러스 외피막에 발현 → 혈액 내에서 안정적인 생존 가능
✅ 정맥주사(IV) 방식으로 투여 가능 → 종양 내 직접 투여보다 치료 접근성이 높아짐
✅ 적은 용량으로도 강력한 항암 효과 확인 → 고형암 및 전이암 치료 가능성
✅ 기존 항암바이러스보다 높은 효능 → 경쟁 기술 대비 기술적 우위 확보
현재 많은 항암바이러스 치료제들이 종양 내 직접 투여 방식을 사용하고 있으나, 정맥주사 방식(IV)으로도 충분한 항암 효과를 나타내는 기술은 매우 희소합니다. 신라젠의 SJ-607이 이러한 기술적 우위를 가지게 되면서, 향후 글로벌 제약사와의 협력 가능성이 높아질 것으로 기대됩니다.



2. SJ-607 국내 특허 등록, 의미와 기대 효과
신라젠은 이번 특허 등록을 통해 지식재산권(IP)을 강화하고, 글로벌 기술 수출의 기반을 마련할 수 있게 되었습니다. 특히 한국은 특허 심사가 까다로운 국가 중 하나인데, 이를 통과했다는 것은 신라젠의 항암바이러스 기술이 독창적이고, 실용적인 가치가 크다는 것을 의미합니다.
1) 국내 특허 등록의 기대 효과
1️⃣ 해외 특허 등록 가능성 증가 → 일본에 이어 미국, 유럽 시장으로 확장 기대
2️⃣ 글로벌 기술 수출 가능성 상승 → 대형 제약사와의 기술 라이선스 계약 유리
3️⃣ 주가 상승 모멘텀 제공 → 바이오 투자자들의 관심 증가
신라젠은 일본에서도 첫 해외 특허를 취득한 바 있으며, 이번 국내 특허 등록을 통해 추후 미국, 유럽 등에서의 특허 확보에도 속도를 낼 것으로 예상됩니다.
또한, 바이오 기업들은 핵심 기술에 대한 특허를 기반으로 글로벌 제약사와 기술이전 계약(라이선스 아웃)을 체결하는 경우가 많습니다. 따라서 이번 특허 등록은 신라젠이 향후 해외 시장에서 기술 수출을 추진하는 데 있어 유리한 조건을 마련하는 중요한 계기가 될 것으로 보입니다.

신라젠 주가 전망과 투자 전략
1. 신라젠 주가 현황
2025년 3월 27일 기준, 신라젠(215600)의 주가는 전일 대비 상승하여 2,380원에 거래되고 있습니다.
- 당일 시가: 2,330원
- 장중 최고가: 2,537원
- 장중 최저가: 2,315원
- 거래량: 약 678,160주
- 52주 변동폭 : 신라젠의 52주 주가 변동폭은 2,270원~5,090원
- 평균 거래량: 540,830주
- 총 시가총액: 약 3,164억 원
- 발행주식수: 137,290,000주
신라젠은 항암바이러스 플랫폼 SJ-607의 국내 특허 등록을 발표하면서 바이오 업계에서 다시 한번 주목받고 있습니다. 이에 따라 투자자들은 향후 주가 변동성과 글로벌 기술 수출 가능성을 면밀히 살펴볼 필요가 있습니다.

2. 신라젠 주가 전망 긍정적 요인
(1) 특허 등록 성공: SJ-607의 국내 특허 등록은 신라젠의 기술력을 인정받은 결과로, 향후 기술 수출 및 파이프라인 확장에 긍정적인 영향을 미칠 것으로 예상됩니다.
(2) 인수합병(M&A) 전략: 신라젠은 안정적인 매출과 영업이익을 갖춘 기업을 흡수합병하는 '플랜A'와 미래 핵심기술에 대한 투자를 진행하는 '플랜B'의 투 트랙 전략을 추진하고 있습니다. 이러한 전략은 기업 가치 상승에 기여할 수 있습니다.
(3) 국내 특허 등록 성공: 기업 가치 상승 기대
(4) 일본 특허 취득 및 글로벌 특허 확대 가능성: 기술 수출 기대감
(5) CDMO 계약 체결(레이테라 협업): 대량 생산 기반 확보
3. 신라젠 주가 전망 부정적 요인
(1) 매출 감소 및 적자 확대: 2024년 9월 전년 동기 대비 매출액은 53% 감소하였으며, 영업손실은 27% 증가하였습니다. 이는 신라젠의 재무 상태에 부정적인 영향을 미칠 수 있습니다.
(2) 주가 변동성: 최근 1년간 주가 변동률이 -49.97%로, 투자자들에게 높은 변동성을 보여주고 있습니다.
투자 전략
(3) 신중한 접근: 신라젠의 주가는 현재 52주 최저가에 도달하였으며, 투자 심리가 위축되고 있습니다. 단기적으로 신중한 접근이 필요합니다.
(4) 임상 시험 진행 여부: 향후 실질적인 임상 성공 여부 중요
(5) 기술 수출 계약 체결 여부: 글로벌 파트너 확보 필수
(6) 경쟁사 대비 기술력 평가: 경쟁 기술 대비 우위 확보 필요
4. 투자자 유의점
바이오 기업의 특성상 임상 시험 및 기술 수출 성과에 따라 주가가 급등 또는 급락할 가능성이 높기 때문에, 신중한 투자 전략이 필요합니다.
단기적으로는 특허 등록 소식이 긍정적인 영향을 미칠 가능성이 크지만, 장기적인 성장을 위해서는 실제 임상 성과와 기술이전 계약 체결이 필수입니다.



신라젠 기업 개요 및 향후 계획
1. 기업개요
(1) 설립연도: 2006년
(2) 주요 사업: 항암바이러스 치료제 개발
(3) 핵심 기술: GEEV® 플랫폼, 항암바이러스 기반 치료제 연구
(4) 주요 파이프라인: SJ-607, SJ-640, SJ-650
2. 신라젠 향후 계획
1️⃣ 국내외 특허 등록 확대 → 미국, 유럽 등 글로벌 시장 공략
2️⃣ 임상 시험 진행 → SJ-607의 임상 1/2상 준비
3️⃣ 기술 수출 추진 → 글로벌 제약사와의 협력 확대
신라젠은 이번 SJ-607 특허 등록을 시작으로 글로벌 시장 진출을 본격화할 계획입니다. 특히 임상 시험 진행과 기술 수출 계약 체결 여부가 향후 신라젠의 기업 가치에 중요한 영향을 미칠 것으로 예상됩니다.



결론: 신라젠, 특허 등록으로 성장 가능성 UP! 주가 전망은?
이번 신라젠의 SJ-607 국내 특허 등록은 기업의 기술력과 미래 성장 가능성을 높이는 중요한 성과입니다. 이를 기반으로 향후 글로벌 특허 등록, 기술 수출 가능성이 확대될 것으로 보이며, 이에 따라 신라젠 주가에도 긍정적인 영향을 미칠 가능성이 높습니다.
그러나 바이오 업종 특성상 주가 변동성이 크므로, 투자자들은 임상 진행 상황과 글로벌 기술 수출 계약 체결 여부를 면밀히 주시할 필요가 있습니다.
향후 신라젠이 추가적인 해외 특허를 확보하고, 글로벌 제약사와의 협력을 통한 기술 수출에 성공할 경우, 기업 가치가 더욱 상승할 가능성이 높다는 점에서 장기적인 성장 가능성에 주목할 필요가 있습니다.
2025.03.13 - [주식정보] - (속보) 신라젠, 코렌텍 우성제약 (수액전문개발) 인수! 신라젠 주가전망은?
(속보) 신라젠, 코렌텍 우성제약 (수액전문개발) 인수! 신라젠 주가전망은?
신라젠(215600)이 코렌텍(104540)으로부터 수액 전문 개발기업 우성제약의 지분 100%를 100억 원에 인수했다고 공식 발표하면서 제약 및 바이오 업계는 물론, 투자자들 사이에서도 큰 관심을 받고 있
yoon.wisespot77.com
2025.02.05 - [주식정보] - 신라젠 주가 전망 최신 업데이트, 신라젠의 미래 가능성은?
신라젠 주가 전망 최신 업데이트, 신라젠의 미래 가능성은?
목차 최근 신라젠이 글로벌 협력 확대와 연구개발 성과를 바탕으로 주가 변동성 속에서 새로운 국면을 맞이하고 있습니다. 특히, 항암 바이러스 플랫폼을 기반으로 한 CDMO 계약과 글로벌 특허
yoon.wisespot77.com
'주식정보' 카테고리의 다른 글
| 사이드카 발동 (사이드카란?)과 미국 트럼프 관세 정책 : 주식시장 불안정성 심화 (0) | 2025.04.07 |
|---|---|
| 공매도란? 공매도 뜻? 공매도 재개! 공매도 효과는? (1) | 2025.04.01 |
| 삼성SDI 유상증자 2조원! 주가전망 유상증자 목적과 영향 (0) | 2025.03.22 |
| 한화에어로스페이스 유상증자 논란 주가하락! 주가현황 주가전망 투자자 대응 전략 (0) | 2025.03.21 |
| (속보) 신라젠, 코렌텍 우성제약 (수액전문개발) 인수! 신라젠 주가전망은? (0) | 2025.03.13 |